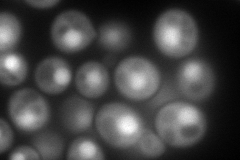
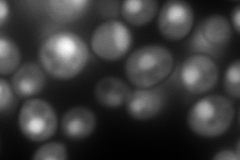
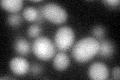
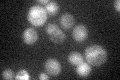

View description
Conserved nuclear protein that interacts with GTP-Gsp1p, which is a Ran homolog of the Ras GTPase family, and stimulates nucleotide release, involved in nuclear protein import, nucleotide release is inhibited by Yrb1p
Localization:
Intensity:
Fold change:
Significance:
-
C’ GFP library in SD

cytosol26.78 -
N' NOP1pr-GFP in SD
cytosol,nucleus227.936 -
N' TEF2pr-mCherry in SD
nucleus508.728 -
N' NATIVEpr-GFP in SD

below threshold18.6991 -
N' TEF2pr-VC and Cyto-VN in SD

#N/A0 -
C’ GFP library in SD+DTT
cytosol36.311.35Yes -
C’ GFP library in SD+H2O2

cytosol23.810.88No -
C’ GFP library in Starvation Media
cytosol30.291.13No -
C’ GFP library on the background of Pup2-DaMP

cytosol -
C’ GFP library on the background of CCT mutant

cytosol33.80321.26186No
